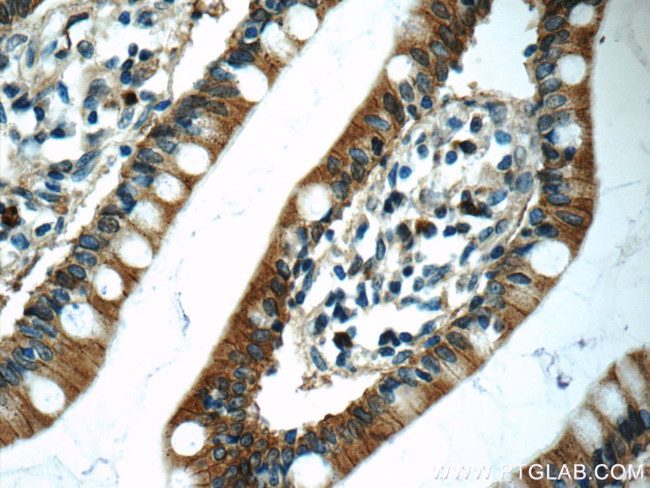
Carboxypeptidase A3 Antibody in Immunohistochemistry (Paraffin) (IHC (P))
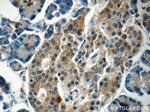
Carboxypeptidase A3 Antibody in Immunohistochemistry (Paraffin) (IHC (P))

Search
Proteintech
Carboxypeptidase A3 Polyclonal Antibody
{{$productOrderCtrl.translations['antibody.pdp.commerceCard.promotion.promotions']}}
{{$productOrderCtrl.translations['antibody.pdp.commerceCard.promotion.viewpromo']}}
{{$productOrderCtrl.translations['antibody.pdp.commerceCard.promotion.promocode']}}: {{promo.promoCode}} {{promo.promoTitle}} {{promo.promoDescription}}. {{$productOrderCtrl.translations['antibody.pdp.commerceCard.promotion.learnmore']}}
产品信息
16236-1-AP
种属反应
宿主/亚型
分类
类型
抗原
偶联物
形式
浓度
纯化类型
保存液
内含物
保存条件
运输条件
产品详细信息
Immunogen sequence: RVSEKESQA IQSALDQNKM HYEILIHDLQ EEIEKQFDVK EDIPGRHSYA KYNNWEKIVA WTEKMMDKYP EMVSRIKIGS TVEDNPLYVL KIGEKNERRK AIFMDCGIHA REWVSPAFCQ WFVYQATKTY GRNKIMTKLL DRMNFYILPV FNVDGYIWSW TKNRMWRKNR SKNQNSKCIG TDLNRNFNAS WNSIPNTNDP CADNYRGSAP ESEKETKAVT NFIRSHLNEI KVYITFHSYS QMLLFPYGYT SKLPPNHEDL AKVAKIGTDV LSTRYETRYI YGPIESTIYP ISGSSLDWAY DLGIKHTFAF ELRDKGKFGF LLPESRIKPT CRETMLAVKF IAKYILKHTS (69-417 aa encoded by BC012613)
靶标信息
Three different forms of human pancreatic procarboxypeptidase A have been isolated. This gene encodes a form which is obtained as a binary complex of a procarboxypeptidase A with proproteinase E and functions as a secretory granule metalloexopeptidase.
仅用于科研。不用于诊断过程。未经明确授权不得转售。
生物信息学
蛋白别名: Carboxypeptidase A3; carboxypeptidase A3 (mast cell); Mast cell carboxypeptidase A; MC-CPA; R-CPA; RMC-CP; tissue carboxypeptidase A
基因别名: CPA3; MC-CPA; mMC-CPA
UniProt ID: (Human) P15088, (Rat) P21961, (Mouse) P15089
Entrez Gene ID: (Human) 1359, (Rat) 54242, (Mouse) 12873